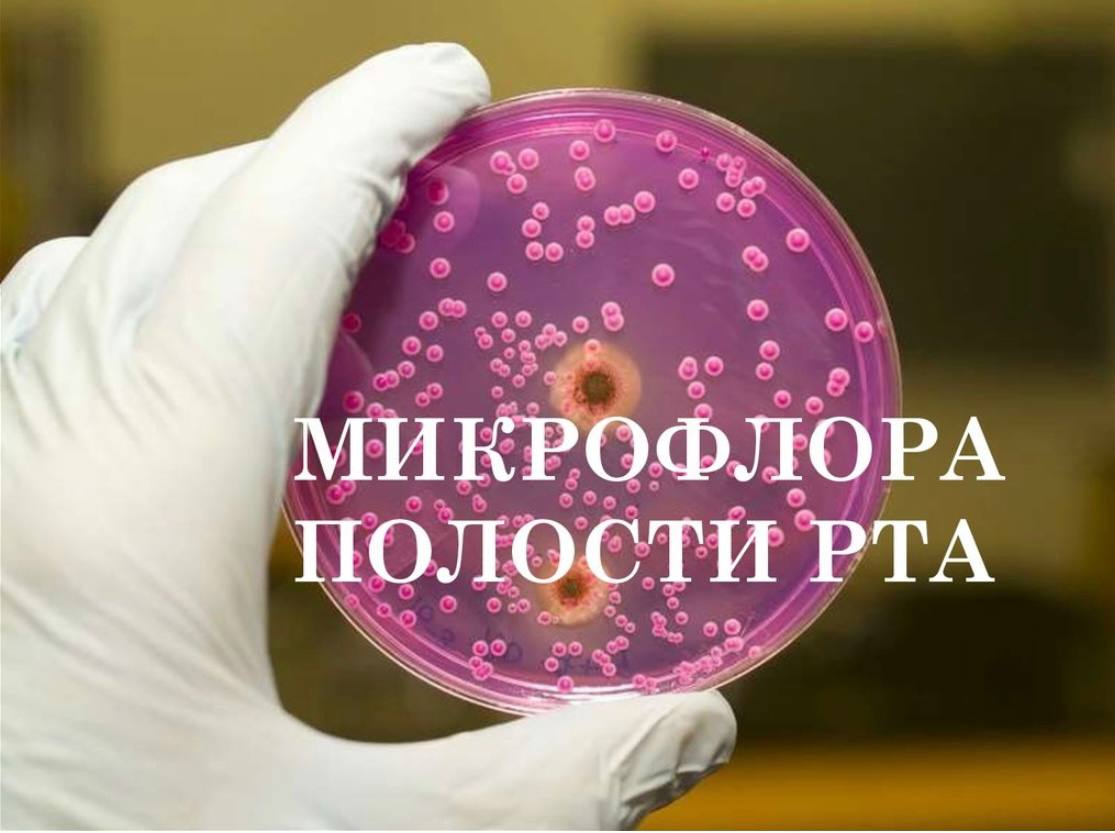

Вымыв микрофлор
Вымыв микрофлор 113 фото
Игроки epic games
Фтор растворим
Китайский визовый центр отзывы
Про хевен роблокс
Фраер не видит
Добрых весенних выходных картинки красивые
Планета спортивные магазины
Служба андрея критского понедельник текст
Этика общения книги
Terminals rdp
20 20 на часах в отношениях
Озеро аргази остров
Рыба тушеная с картофелем
Майнкрафт пе жажда и температура
Тонер 5000
Включи запрещенный майнкрафт
Моноблок форум
Московский романс режиссер
Срочно нужен хозяин
Сейба природная зона южная америка